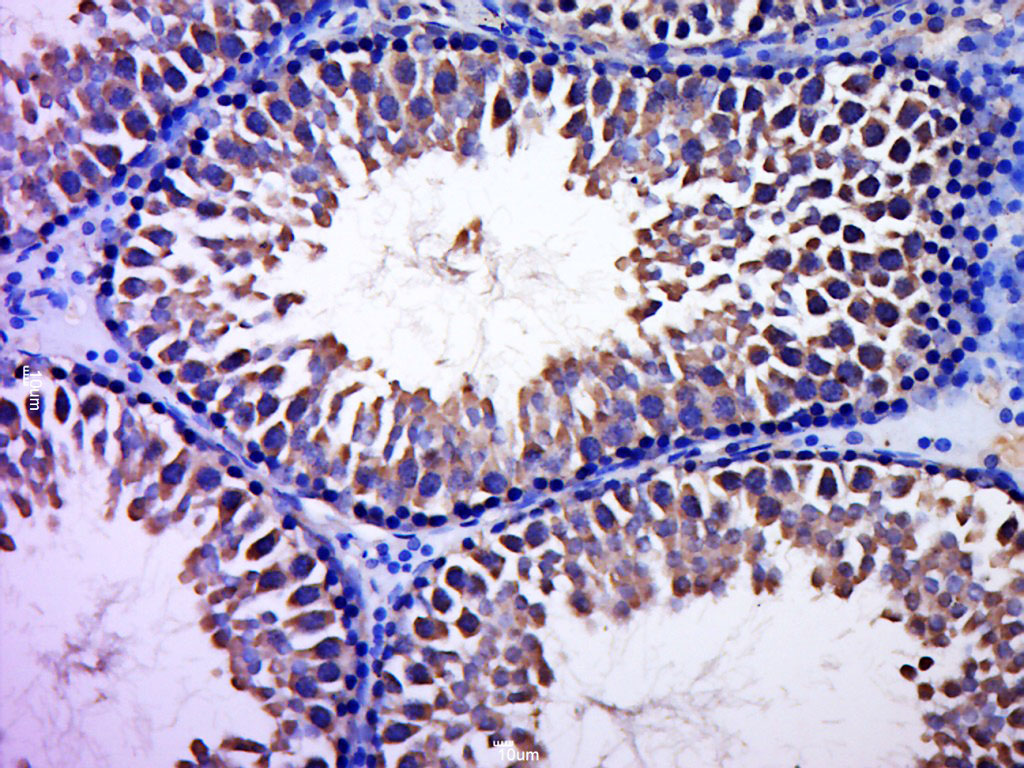
Paraformaldehyde-fixed, paraffin embedded rat testis; Antigen retrieval by boiling in sodium citrate buffer (pH6.0) for 15min; Block endogenous peroxidase by 3% hydrogen peroxide for 20 minutes; Blocking buffer (normal goat serum) at 37°C for 30min; Antibody incubation with CCDC93 Polyclonal Antibody, Unconjugated (bs-8143R) at 1:400 overnight at 4°C, followed by a conjugated secondary for 20 minutes and DAB staining.

CCDC93 Antibody (aa293-631, clone OTI2D2)
LS-C336979
ApplicationsWestern Blot
Product group Antibodies
ReactivityCanine, Human, Monkey
TargetCCDC93
Overview
- SupplierLifeSpan BioSciences
- Product NameCCDC93 Antibody (aa293-631, clone OTI2D2)
- Delivery Days Customer23
- ApplicationsWestern Blot
- Applications SupplierWB (1:500)
- CertificationResearch Use Only
- ClonalityMonoclonal
- Clone IDOTI2D2
- Concentration1 mg/ml
- ConjugateUnconjugated
- Estimated Purity...
- Gene ID54520
- Target nameCCDC93
- Target descriptionCCC complex scaffolding subunit CCDC93
- Target synonymscoiled-coil domain-containing protein 93, coiled-coil domain containing 93
- HostMouse
- IsotypeIgG1
- ReactivityCanine, Human, Monkey
- Storage Instruction-20°C
- UNSPSC12352203